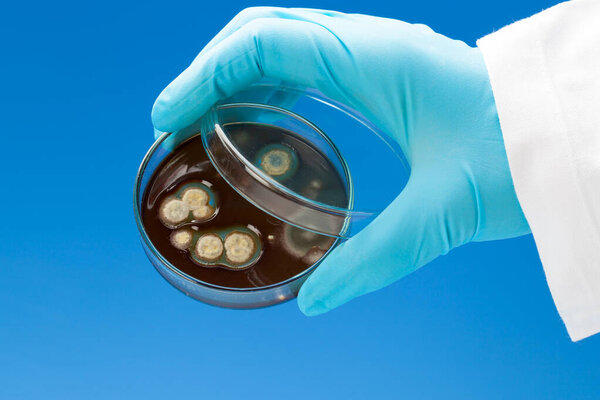
Hand in nitril glove holds Petri dish with bacterial colonies
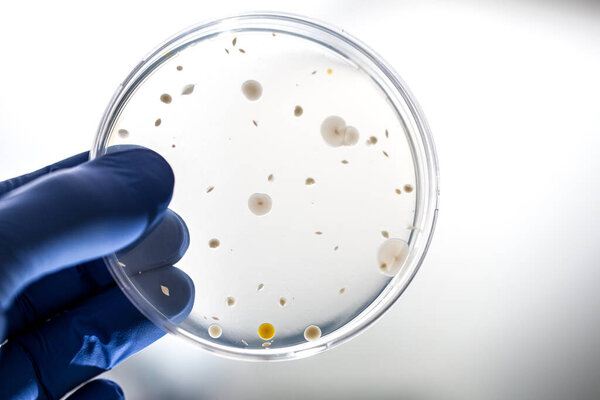
Hand of doctor with blue gloves holding test sample

- /
- Search /
- petri dish with bacterial colonies in the hand, on blue backgro
petri dish with bacterial colonies in the hand, on blue backgro
Petri dish with bacterial colonies in the hand, on blue background
image
image
Jun.03, 2013 15:46:12
10.65
0.69
343x500
685x1000
1371x2000
2702x3943
2702x3943
637
15
motorolka
RED WHITE BLUE ROUND BACKGROUND ON CLOSE UP MACRO GLASS CLOSEUP MICRO HEALTH PLATE DISH PLASTIC HANDS HAND COAT BACTERIAL BIOLOGICAL WITH PART BODY DISEASE CULTURE BIOLOGY LAB LABORATORY SCIENCE IN RESEARCH GLOVE SCIENTIFIC CYAN MICROBE ISLAND FUNGI THE BACTERIA MICROBIOLOGY COLONY FUNGAL MOLD COLONIES PETRI AGAR COLI BACKGRO NITRIL